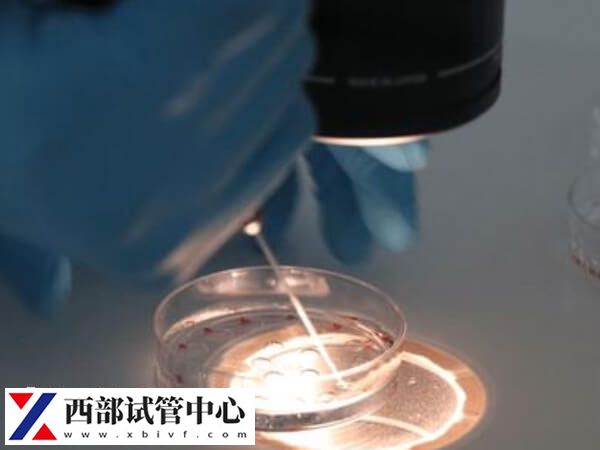
移植嵌合體百分之30胚胎有什么風險

?
搡BBBB搡BBB搡五十|
女被啪到高潮的GIF动态图无遮|
久久亚洲色WWW成人欧美|
毛片TV网站无套内射TV网站|
欧美疯狂3p群体交乱视频丨zu
|
白天躁晚上躁天天躁|
第一次爱的人视频播放完整版免费
|
国精一二三区别免费|
久久久久蜜桃精品成人片
|
亚洲精品亚洲人成在线观看麻豆|
亚洲AV成人永久网站www在线|
三上悠亚被弄到痉挛惨叫AV|
小洁和公H文翁17|
亚洲最大的成人网站|
啊灬啊灬啊灬快灬高潮了|
国产成人无码AV在线播放DVD|
亚洲一线产区二线产区区别在哪里
|
国产果冻豆传媒麻婆精东影视|
宝宝两根就哭男男是不是太早了
|
精品无码国产自产拍在线观看蜜桃|
丰满妇女强高潮18ⅩXXX在线|
爱性久久久久久久久|
波多野结衣av无码久久一区|
亚洲精品无码AⅤ片影音先锋在线
亚洲精品无码AⅤ片桃花岛
|
国产伦精品免编号公布|
色天使色偷偷色噜噜噜AV天堂|
成人Av无码一区二区三区|
新CHINESE无套小帅KTV|
亚洲AV五十路在线观看|
亚洲人亚洲精品成人网站|
伊人涩涩涩涩久久久AV
|
狠狠五月激情六月丁香|
国产精品天干天干在线观看澳门|
国产精品福利自产拍在线观看|
国产乱来乱子视频|
国产香蕉97碰碰视频VA碰碰看|
精品九九人人做人人爱|
久久鬼色综合88久久|
久久毛片免费看一区二区三区|
蜜臀久久99精品久久久久久小说|
免费拗女网站1300部|
人人模人人爽人人喊久久|
免费无码成人AV电影在线播放
|
亚洲 欧美 国产 动漫 综合|
真人作爱90分钟免费看视频|
BRAZZERSHD欧美大屁股|
亚洲人成无码网站在线观看野花|
性色A∨人人爽网站HD|
亚洲AV中文无码乱人伦在线R▽|
国产无线乱码一区二三区|
啊灬啊灬啊灬快灬高潮了老|
黑人粗大猛烈XXⅩXXBB|
人妻丰满熟妞AV无码区|
亚洲精品成人久久AV|
BBW大屁股肥臀妇女ASS|
国精产品一区一区三区有限公司|
免费看又黄又爽又猛的视频|
无码AV动漫精品专区|
亚洲老熟女 @ TUBEUM|
99国精产品灬源码1688|
国产极品熟女沙发内射AV|
久久99精品九九九久久婷婷
|
精品高潮呻吟99AV无码视频|
男生把感叹号放进女生的括号|
少妇18p一区二区三区|
西西人体自慰扒开下部93|
宅男66LU国产在线观看|
国产女主播喷水视频在线观看
|
日本极品少妇XXXX|
永久免费男同AV无码入口|
国产猛进猛出又黄又爽又色|
人人妻人人做从爽精品|
与子乱刺激对白在线播放|
国产一区二区三区好的精华液|
日产2021免费一二三四区|
在线观看亚洲AV每日更新|
国内少妇毛片视频|
熟女俱乐部五十路六十路AV|
99RE6热这里只精品首页|
久久精品AⅤ无码中文字字幕蜜桃|
无码人妻精品一区二区三|
成码无人AV片在线电影网站|
妺妺窝人体色777777|
亚洲熟妇无码AV在线少妇|
国产欧美日韩免费看AⅤ视频|
日韩精品无码人成视频手机|
97久久久久人妻精品区一|
久久精品国产2020观看福利|
校花娇喘呻吟校长陈若雪视频|
成在人线AV无码免费高潮喷水|
女朋友喊疼男生的心理活动知乎|
亚洲最大成人AV在线天堂网|
和丰满少妇作爱过程视频|
无码人妻AⅤ一区二区三区水密桃|
成年女人毛片免费观看97|
欧美猛少妇性ⅩXXX|
中文字幕大香视频蕉|
久久久久国产精品熟女影院|
亚洲国产精品无码久久一区二区|
国产精品毛片一区二区|
熟妇高潮精品区一区二区三|
となりの家のネツト在线
|
成人欧美日韩一区二区三区|
久久伊人少妇熟女大香线蕉|
人与畜禽共性关系的重要性有哪些|
最新系列国产专区|亚洲国产|
亚洲AV无码乱码国产精品久久|
亚洲精品国自产拍在线观看
|
少妇被三个黑人调教|
WWW.五月激情.COM|
欧美丰满美乳XXⅩ高潮www|
中文亚洲AV片在线观看不卡|
巨大黑人XXXXX高潮后处理|
亚洲中文字幕无码爆乳AV|
精品国产成人一区二区|
亚洲成人av免费观看|
黑人双人RAPPER剧情介绍|
亚洲AV乱码一区二区三区按摩|
国产三级A三级三级|
性色AV一区二区三区咪爱四虎|
国产内射老熟女AAAA∵|
乌克兰美女的小嫩BBB|
国产成人无码A区在线观看视频免
国产成人无码A区在线观看视频A
国产成人无码A区在线观看视频
|
亚洲一区二区三区在线网址|
久久WWW成人看片免费不卡|
亚洲免费福利视频|
久久99国产精品二区|
亚洲综合久久一区二区|
久久熟女俱乐部五十路二区av|
伊人久久大香线焦AV色|
麻豆国产AV超爽剧情系列|
中文字幕乱码无码人妻系列蜜桃|
美女露�0裸体无档动态视频|
91人人妻人人澡人人爽超污|
欧美亚洲国产精品久久高清|
波多野结衣HD在线观看|
少妇又爽又刺激视频|
国产精品国产精品偷麻豆
|
日产精品乱码卡一卡2卡三网站|
成年女人天堂香蕉网|
特级毛片AAAAAA|
国产色综合天天综合网|
亚洲爆乳AⅤ无码一区二区|
精品久久久久久中文字幕大豆网|
亚洲无熟妇成人无码|
美女高潮20分钟视频在线观看|
99RE热这里只有精品|
人妻少妇一区二区三区|
公侵犯玩弄熟睡人妻电影|
午夜成人性爽爽免费视频|
极品尤物爆乳自慰呻吟|
野花香电视剧全集免费观看
|
天堂中文资源库官网|
国产一区二区三区美女|
亚洲色成人一区二区三区|
米奇7777狠狠狠狠视频影院|
ZLJZLJZLJ日本人水多多|
少妇人妻精品一区二区|
国内精品自线在拍大学生|
野花社区高清在线观看视频|
欧美V日韩V亚洲V最新在线观看
|
日韩AV无码一区二区三区|
国产成人精欧美精品视频|
亚洲AV无码片区一区二区三区|
久久久精品无码中文天美|
99国产亚洲精品美女久久久久|
骚片AV蜜桃精品一区|
国产无遮挡又黄又爽又色|
亚洲伊人久久大香线蕉|
欧美精产国品一二三产品|
国产AV成人精品播放|
亚洲国产AV一区二区三区丶|
美女张开双腿久久久久久|
车子一晃一晃的就C进去了肉|
亚洲 欧美 激情 小说 另类|
久久先锋男人AV资源网站|
波多野结衣人妻厨房大战|
性亚洲VIDEOFREE高清极|
乱人伦中文视频在线|
刺激交换经历过程小说|
亚洲AV永久无码成人网站|
免费女人高潮流视频在线观看|
成人无码精品一区二区三区|
亚洲A∨无码一区二区|
免费无遮挡色视频网站|
跪趴式啪啪GIF动态图27报|
美女把尿口扒开让男人桶爽|
国产在线乱子伦一区二区|
成人免费AⅤ视频一区二区|
亚洲乱码卡1卡2新区3|
天天天狠天天碰天天爱|
2021最新久久久视精品爱|
少妇被粗大的猛烈进出96影院|
狠狠色噜噜狠狠狠狠AV|
99久久免费只有精品国产|
午夜男女爽爽羞羞影院在线观看|
麻豆av无码人妻一区二区三区
|
欧美性猛尖ⅩⅩⅩⅩ乱大交|
国产日韩精品欧美一区喷水|
99精产国品一二三产区|